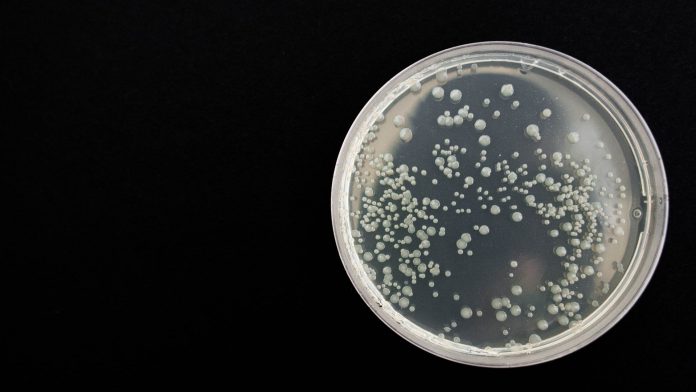

Scientists at Rockefeller University, US, have discovered a new family of antibiotics in samples of soil which could prove significant in the battle against antimicrobial resistance.
The compounds discovered are called malacidins, and tests have shown them annihilate several of the bacterial diseases that have become resistant to most existing antibiotics, including the MRSA superbug, prompting hope they may signify a new family of antibiotics.
Antibiotic-resistant diseases continue to be a major global health issue, being responsible for the deaths of nearly 700,000 people every year.
New antibiotics thus urgently need to be developed.
The team at Rockefeller University, led by Dr Sean Brady, used a gene sequencing technique to analyse over 1,000 soil samples taken from across the US.
Once the malacidins were discovered, the compound was tested on rats that had been given MRSA and resulted in the infection in skin wounds being eradicated.
When can it be tested on humans?
Now the new discovery has been made, researchers are looking to improve the effectiveness of the drug so that it can be developed into a proper treatment for human use.
Brady said: “It is impossible to say when, or even if, an early stage antibiotic discovery like the malacidins will proceed to the clinic.
“It is a long, arduous road from the initial discovery of an antibiotic to a clinically used entity.”
Gram-negative bacteria
Most bacteria are put into two groups, Gram-positive or Gram-negative, which is based on the Gram stain test developed in the 1800s by Hans Christian Gram, a method of classifying different types of bacteria using a chemical stain.
Gram-negative bacteria are those resistant to most antibiotics.
Professor Colin Garner, from Antibiotic Research UK, added: “Our concern are the so-called ‘Gram-negative’ bacteria which are difficult to treat and where resistance is on the increase.
“Gram-negative bacteria cause pneumonia, blood and urinary tract infections as skin infections. We need new antibiotics to treat this class.”









